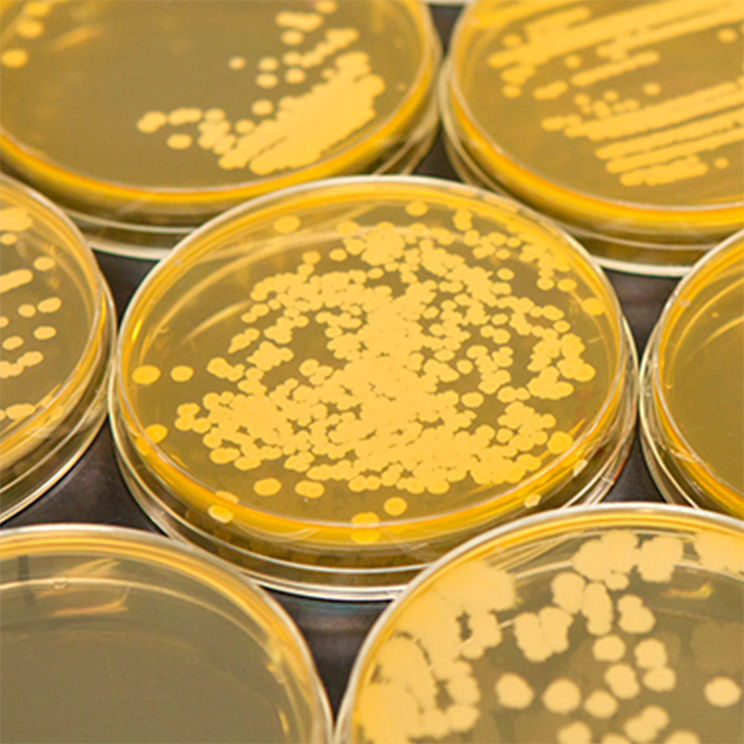

日本の納豆用大豆を
海外へ持ち込む
1970年より⽇本の納⾖⽤の⼩粒⼤⾖(茨城納⾖⼩粒)を
現地(アメリカ・カナダ)に持ち込み、
栽培改良を重ね今⽇の納⾖⽤⼤⾖があります。
おかめ納豆になれる「最高の大豆」をいつも探し求めています。

2,200種以上の
納豆菌を収集・ストック
納豆は納豆菌の働きによって、うま味やにおい、味なども変わってきます。タカノフーズの納豆研究所では2,200種もの納豆菌を収集・ストック。それぞれの菌の持つ特徴を生かした商品作りを行っています。美味しさや、健康に貢献するまだ見ぬ納豆菌を求めて。
納豆菌の研究は奥深く、無限の可能性が広がっていると信じています。


お互いを引き立てる
絶妙なバランスのタレ
納豆のタレは例えるなら名脇役。
納豆本来の旨みを引き立てるために存在しています。
でしゃばらず、引き過ぎない、
お互いを引き立てる絶妙なバランスを目指して、
1つの商品を開発するにあたり、
50種類以上のタレを試作することも。


人間の五感で品質を
チェック
味やにおいといった「納豆のおいしさ」は
検査機器だけでは測定しきれません。
そこで人間の五感によって納豆のおいしさを判定する
「官能検査」を行っています。
出荷した納豆が食卓に上ったときに
ちょうど食べごろとなることを想定して、
1日、数十個の納豆を試食し、チェックしているのです。


より新鮮な納豆を
お届けするために
タカノフーズでは、納豆は野菜と同じ
「生鮮食品」だと考えています。
心をこめて丁寧につくった商品のおいしさをより感じていただくため食べごろとなるタイミングを計算して出荷しています。
そのためおかめ納豆の工場は北海道から九州まで全国各地に存在します。
いつも食卓に、
おいしさと
笑顔を。
おかめ納豆は、これからも
みなさまの健康づくりを
応援してまいります。




